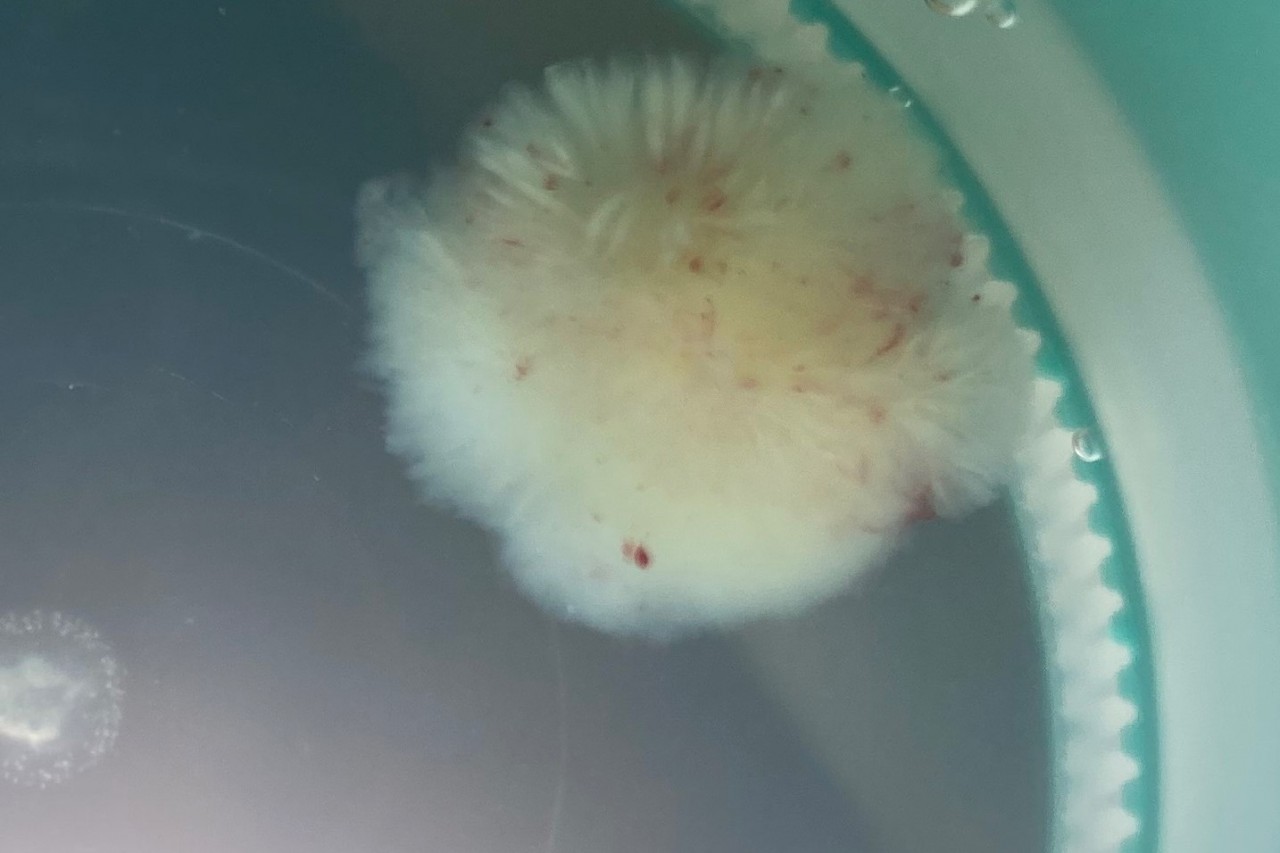
1 Папиллярная фиброэластома

«С сердцем у меня проблем никогда не было. А в январе этого года я вдруг впервые почувствовала жгучую боль в районе горла, словно кипятком облили изнутри. Вызвали скорую. Приехавшая бригада сняла кардиограмму, убедилась, что инфаркта у меня нет, и уехала. Боль постепенно прошла», — рассказывает жительница Великого Новгорода.
После этого случилось еще несколько подобных приступов, и каждый раз врачи разводили руками, пока в марте очередная кардиограмма действительно не показала инфаркт миокарда. Тогда женщину срочно госпитализировали и выполнили коронарографию (исследование, при котором в коронарную артерию заводится диагностический катетер, вводится контрастное вещество и выполняется серия снимков). Картина в разных проекциях менялась — в одних было видно, что есть препятствие кровотоку, на других этого препятствия не было. Врачи предположили, что у пациентки диссекция (расслоение внутренней оболочки правой коронарной артерии), и выполнили стентирование. Установленный стент должен был закрепить отслоившуюся часть артерии и прекратить приступы. Однако, вопреки ожиданиям, после стентирования женщина снова почувствовала боль.
Тогда новгородские специалисты обратились за помощью к врачам Центра Алмазова, и, чтобы не тратить драгоценное время, женщина срочно была транспортирована в Санкт-Петербург.
«Выполнив дополнительные обследования, мы нашли истинную причину приступов. Оказалось, у пациентки была папиллярная фиброэластома (достаточно редкая форма доброкачественной опухоли сердца). Она очень часто долго протекает бессимптомно, поскольку ее размер не превышает 1,5–2 см. Проявиться она может в виде нарушения мозгового кровообращения, когда или фрагменты самой опухоли, или тромботические массы отрываются и с током крови попадают в сосуды головного мозга. У нашей пациентки случилось по-другому — фиброэластома вызвала инфаркт миокарда», — вспоминает заведующий отделением сердечно-сосудистой хирургии № 1 Центра Алмазова Александр Станиславович Гневашев.
Наиболее часто папиллярная фиброэластома крепится к аортальному клапану или к стенкам аорты на тонкой ножке, а с током крови может временно заноситься в устье коронарной артерии, прекращая кровоток по ней. При этом у больного возникают боли в груди, очень типичные для стенокардии, позже, когда опухоль покидает устье, симптомы проходят. Исследования, выполненные новгородскими врачами, несколько раз не показывали стенокардию или инфаркт именно потому, что в этот момент опухоль перемещалась и открывала кровоток.
«Внешне папиллярная фиброэластома похожа на анемоны — коралловые полипы (небольшое мягкое, пушистое образование, крепящееся на тонкой ножке). А поскольку диаметр устья коронарной артерии всего 4–5 мм, то эту «пушинку» периодически туда заносило. Она перекрывала кровоток, миокард терпел бедствие и реагировал болевым синдромом», — комментирует врач — сердечно-сосудистый хирург НМИЦ им. В. А. Алмазова Дмитрий Валериевич Бендов.
К счастью, несмотря на перенесенный инфаркт и стентирование, у женщины сохранена сократительная способность миокарда. Сразу после поступления в Центр Алмазова, в день госпитализации ей была выполнена кардиохирургическая операция, в ходе которой папиллярная фиброэластома удалена.
Послеоперационный период прошел без осложнений. Однако в связи с тем, что у пациентки в коронарной артерии остался стент (удалить его невозможно), ей предстоит принимать специальные препараты против закупорки, которая может произойти в силу физиологических причин — реакции организма на инородное тело и заполнение его клетками внутреннего слоя коронарного сосуда.


